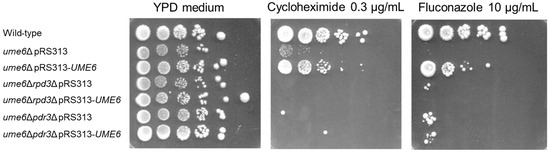

Abstract
In Saccharomyces cerevisiae, the Rpd3L complex includes the histone deacetylase Rpd3 and the DNA binding proteins Ume6 and Ash1 and serves as a transcriptional silencer or enhancer. In S. cerevisiae, the transcription of PDR5, which encodes a major drug efflux pump, and pleiotropic drug resistance (PDR) are hyperactivated by the transcription factor Pdr3 in ρ0/− cells, which lack mitochondrial DNA. We previously showed that RPD3 and UME6 are required for the activation of PDR5 transcription and PDR in S. cerevisiae ρ0 cells. Here, using real-time PCR analysis, we revealed that RPD3 and UME6 are responsible for the activated basal expression of the ABC transporter-encoding genes SNQ2, PDR15, and PDR5 in S. cerevisiae ρ0 cells. Furthermore, using real-time PCR analysis and a spot dilution assay, we found that Ume6 increases the basal expression of PDR5 and PDR15 and induces PDR in a manner dependent on RPD3 and PDR3 in ρ0 cells. This finding may contribute to the elucidation of the relationships between the molecules required for the activation of ABC transporter genes in S. cerevisiae ρ0/− cells and in pathogenic Candida species.
1. Introduction
Multidrug resistance refers to the acquired resistance of cancer cells and microorganisms to a wide variety of chemotherapeutic drugs [1,2]. Therefore, multidrug resistance is a serious concern in the treatment of cancer and microbial infections. In mammalian cells, overexpression of the MDR1 gene, which encodes P-glycoprotein, an ATP-binding cassette (ABC) transporter, is a major mechanism underlying multidrug resistance in cancer cells [3,4,5]. Yeast Candida species Candida albicans and Candida glabrata are opportunistic pathogenic microorganisms [1]. In pathogenic Candida species, the most prevalent mechanism of multidrug resistance involves increased activity of ABC transporters and major facilitator superfamily pumps [6,7,8]. Therefore, the elucidation of multidrug resistance mechanisms in cancer cells and Candida species is needed to develop anticancer and antifungal drugs that overcome multidrug resistance [3,9,10].
The yeast Saccharomyces cerevisiae is used as a model organism for studies of multidrug resistance in pathogenic Candida species [11]. The resistance phenotype of S. cerevisiae to a broad range of cytotoxic compounds is referred to as pleiotropic drug resistance (PDR) [12]. PDR in S. cerevisiae is often associated with the overexpression of plasma membrane ABC transporters [13,14,15]. Plasma membrane ABC transporters, such as Pdr5, Snq2, and Yor1, export a variety of functionally and structurally unrelated compounds from cells [13,16,17]. PDR5 encodes a major efflux pump of structurally and functionally unrelated drugs and xenobiotics, such as fluconazole and cycloheximide [18,19].
The transcription of the ABC transporter genes PDR5, SNQ2, YOR1, PDR10, and PDR15 in S. cerevisiae is controlled by the paralogous transcription factors Pdr1 and/or Pdr3 [13,17,20]. DNA consensus motifs, termed pleiotropic drug response elements (PDREs), are located in the promoter regions of PDR5, SNQ2, YOR1, PDR10, and PDR15 and are recognised by Pdr1 and/or Pdr3 [13,17,20,21]. Two PDREs are located in the promoter region of PDR3 and are recognised by Pdr3 and Pdr1 [22]. Thus, Pdr3 positively autoregulates the transcription of PDR3 via these two PDREs [22]. Although the functions of Pdr1 and Pdr3 in PDR are partially redundant, Pdr1 plays a major role in PDR and basal PDR5 expression [17,23]. Gain-of-function mutations in PDR1 and PDR3 (e.g., pdr1-3 and pdr3-7) increase the expression of PDR3, PDR5, SNQ2, YOR1, PDR10, and PDR15 to activate PDR [14,15,24].
The retrograde signalling pathway is strongly activated in S. cerevisiae and C. glabrata ρ0/− cells, which have mitochondrial DNA defects [25,26]. Deletion of mitochondrial DNA in C. glabrata cells results in increased expression of multidrug resistance genes, including CgCDR1, and increased PDR. Pdr3 but not Pdr1 is strongly activated in S. cerevisiae ρ0/− cells; therefore, the transcription of ABC transporter genes such as PDR5 and PDR is hyperactivated [27]. It has previously been reported that the Hsp70 chaperone Ssa1, the mitochondrially localised phosphatidylserine decarboxylase Psd1, the subunit of the RNA polymerase II mediator complex Med12, and the histone H2 ubiquitination enzyme Lge1 are required for the activation of ABC transporter gene transcription and PDR in S. cerevisiae ρ0/− cells. Pdr3 is negatively regulated by the Hsp70 protein Ssa1 through a direct interaction [28]. Furthermore, less Ssa1 is bound to Pdr3 in ρ0 cells than in ρ+ cells, which contain mitochondrial DNA, suggesting the release of Pdr3 from the negative regulation of Ssa1 in ρ0 cells [28]. Deletion of Med12 completely suppresses the induction of PDR5 expression in ρ0 cells but not in ρ+ cells [29]. Psd1 is involved in phosphatidylethanolamine (PE) synthesis, and loss of the PSD1 gene from ρ0 cells prevents the normal activation of PDR5 [30]. In addition, the expression of a catalytically inactive form of Psd1 induces PDR5 transcription in ρ0 cells [30]. Lge1 is indispensable for the induction of PDR5 transcription in ρ0 cells [31,32]. However, the relationships among these molecules required for the activation of ABC transporter genes in ρ0 cells are unknown.
Hda1 and Rpd3 are the key lysine deacetylases for antifungal resistance in S. cerevisiae ρ+ cells [33]. Although the histone deacetylase Rpd3 is required for Hsp90-dependent antifungal resistance, it is not required for Pdr5-mediated PDR in S. cerevisiae ρ+ cells [33]. In S. cerevisiae, the Rpd3L complex participates in chromatin remodelling and transcriptional repression [34,35,36]. The Rpd3L complex contains Rpd3, the transcriptional scaffold and corepressor Sin3, the histone chaperone Ume1, and the sequence-specific DNA binding proteins Ume6 and Ash1 [36,37]. The Rpd3L complex is recruited to target gene promoters by Ume6 or Ash1 [38]. For example, Ume6 is known to bind to upstream repressor sequence 1 (URS1) in many early meiotic genes (EMGs) [39]. The Rpd3L and Isw2 chromatin remodelling complexes are recruited to EMG promoters by Ume6 [35,40]. Thus, the Rpd3L and Isw2 chromatin remodelling complexes repress EMG expression by hypoacetylation of histone H3 and histone H4 during mitotic growth [34,38,41]. In addition to their roles as transcriptional repressors, Ume6 and Rpd3 play roles as transcriptional activators. The meiosis-specific transcriptional activator Ime1 binds to Ume6 and converts Ume6 from a transcriptional repressor to a transcriptional activator to release EMGs from repression [42]. Rpd3 functions as a transcriptional activator for the anaerobic genes DAN/TIR and osmoresponsive genes [43,44].
We previously showed that RPD3 and UME6 are required for the hyperactivation of PDR5 transcription and PDR via retrograde signalling in S. cerevisiae ρ0 cells [45]. In contrast, we also previously reported that Ume6 suppresses the basal transcription of ABC transporters, including PDR5, and the PDR in ρ+ cells; however, RPD3 is required for drug resistance but does not alter the basal PDR5 mRNA level [46].
Here, we show that RPD3 and UME6 are responsible for the activated basal expression of not only PDR5 but also SNQ2 and PDR15 in S. cerevisiae ρ0 cells. We also show that UME6 increases the basal expression of PDR5 and PDR15 and increases the PDR in a manner dependent on RPD3 and PDR3 in ρ0 cells.
2. Materials and Methods
2.1. Yeast Strains, Plasmids, and Media
The FY1679-28C (MATa, ura3-52, leu2-D1, trp1-D63, his3-D200, GAL2+) strain was used as the wild-type strain [45,46,47,48,49]. To construct its derivatives with single or double gene deletions, the open reading frames of UME6, PDR3, or RPD3 were replaced with KanMX or bleMX6 gene cassettes by PCR-mediated one-step gene disruption in the FY1679-28C background [45,46,49]. The ρ0 derivatives of the strains described above were obtained by plating the cells once on YPD agar plates (2% glucose, 1% yeast extract, 2% Bactopeptone, and 2% agar) containing 40 μg/mL of ethidium bromide [50]. The yeast strains used in this work are listed in Table 1.

Table 1.
Yeast strains used.
The centromeric plasmid pRS313 (cen, HIS3) was purchased from the National Bio-Resource Project, Japan [51]. UME6 was PCR-amplified from genomic DNA using PrimeSTAR GXL Polymerase (TaKaRa) and the following primers homologous at −405 and +3011: UME6 forward, 5′-GGCGTCGACTATACAAAAGCGACACGTCGTCTGA-3′ (the underline is the SalI recognition sequence) and UME6 reverse, 5′-CCGCCCGGGCAATGAATTTTGCAAATCCAACGTG-3′ (the underline is the XmaI recognition sequence). The resulting PCR product and the pRS313 plasmid were digested with XmaI and SalI. The digested PCR product was cloned and inserted into the linearised pRS313 plasmid using DNA Ligation Kit Mighty Mix (TaKaRa Bio Inc., Shiga, Japan). The resulting plasmid was termed pRS313-UME6.
Yeast cells were grown in YPD medium (2% glucose, 1% yeast extract, 2% Bactopeptone) at 30 °C.
2.2. Spot Dilution Assay
The relative resistance of each yeast strain to fluconazole or cycloheximide was estimated with a spot dilution assay using YPD media [45,46,49]. The ρ0 cells from each yeast strain were aerobically grown to the logarithmic phase (at an OD600 of 0.6–0.9) at 30 °C in YPD media in triplicate. Five microlitre aliquots of 10-fold serial dilutions of cultures containing the same number of cells were spotted on YPD plates with or without 10 μg/mL of fluconazole (Nacalai Tesque, Kyoto, Japan) (or 0.3 μg/mL of cycloheximide (Wako Pure Chemicals, Osaka, Japan)) and incubated at 30 °C for 7 days.
2.3. RNA Extraction from ρ0 Cells of Each Yeast Strain Grown to the Logarithmic Growth Phase
ρ0 cells from each yeast strain were grown to an OD600 of 7–9 in YPD media in duplicate. The cultures were diluted to an OD600 of 0.1 and grown to an OD600 of 0.4–0.8 [45,46,49]. The cultures were recovered, and the cells in the cultures were pelleted, washed, frozen at −80 °C, and used for total RNA extraction [45,46,49]. Total RNA was isolated from the yeast cells using a NucleoSpin RNA kit (TaKaRa Bio Inc., Shiga, Japan) according to the manufacturer’s protocol.
2.4. Real-Time RT–PCR
Reverse transcription of total RNA was performed using FastGene Scriptase II cDNA 5× ReadyMix (NIPPON Genetics, Tokyo, Japan) and oligo dT primers (TaKaRa Bio Inc., Shiga, Japan). SYBR Green qRT–PCR for cDNA from the individual duplicate samples was performed using TB Green Premix Ex Taq II (TaKaRa Bio Inc., Shiga, Japan) in a Step One Real-time PCR system (Applied Biosystems, Foster City, CA, USA) [52]. A minus reverse transcriptase control was used as the negative control. Serial dilutions of control cDNA were prepared to produce a standard curve for each primer pair. The primers used for qRT–PCR are listed in Table S1. The mRNA levels of each target gene were measured by qRT–PCR and normalised to those of the housekeeping gene ACT1, which was used as an endogenous control. The normalised mRNA levels are shown relative to samples from the wild-type strains, which were set to 1.
2.5. Statistical Analysis
An unpaired Student’s t-test was used for statistical analysis. Results with p < 0.05 and p < 0.01 were considered statistically significant.
3. Results
3.1. UME6 and RPD3 Are Required for the Upregulation of the Steady-State mRNA Levels of SNQ2, PDR15, and PDR5 in ρ0 Cells
We previously reported that activated PDR5 transcriptional expression by retrograde signalling was significantly reduced in ρ0 cells of the rpd3Δ and ume6Δ strains. Thus, we investigated the mRNA levels of the major ABC transporter genes PDR15, PDR10, SNQ2, and YOR1, including PDR5, in ρ0 cells of the wild-type, ume6Δ, and rpd3Δ strains by qRT–PCR. qRT–PCR revealed that the YOR1, SNQ2, PDR15, PDR10, and PDR5 mRNA levels were statistically significantly lower in the ume6Δ strain than in the wild-type strain (p < 0.05) (Figure 1). In contrast, the expression of SNQ2, PDR15, and PDR5, but not that of YOR1 or PDR10, was statistically significantly lower in the rpd3Δ strain than in the wild-type strain (p < 0.05) (Figure 2). In both the ume6Δ and rpd3Δ mutants, although the SNQ2 mRNA levels were relatively mildly reduced, the mRNA levels of SNQ2, PDR15, and PDR5 were reduced compared with those in the wild-type strain (Figure 1 and Figure 2). These results suggest that SNQ2, PDR15, and PDR5 are upregulated by Ume6 via Rpd3 in ρ0 cells.

Figure 1.
Transcription levels of ABC transporters in ρ0 cells of the wild-type and rpd3Δ strains in the logarithmic growth phase. Relative YOR1, SNQ2, PDR15, PDR10, and PDR5 mRNA levels in ρ0 cells of the wild-type and ume6Δ strains in the logarithmic growth phase were determined by qRT–PCR. One asterisk (*) or two asterisks (**) indicate p values less than 0.05 or 0.01, respectively.

Figure 2.
Transcription levels of ABC transporters in ρ0 cells of the wild-type and rpd3Δ strains in the logarithmic growth phase. The relative transcription levels of YOR1, SNQ2, PDR15, PDR10, and PDR5 were determined in ρ0 cells of the wild-type and rpd3Δ strains in the logarithmic growth phase by qRT–PCR. One asterisk (*) or two asterisks (**) indicate p values less than 0.05 or 0.01, respectively.
3.2. RPD3 and PDR3 Are Required for the Partial Rescue of the Reduction in PDR15 and PDR5 Expression in the ume6Δ Strain by Exogeneous UME6 Expression
To validate whether reduced mRNA levels of PDR15 and PDR5 in the ume6Δ mutant result from the deletion of UME6, we investigated whether decreased mRNA levels of PDR15 and PDR5 in the ume6Δ mutant are complemented with exogeneous expression of UME6. Although PDR15 and PDR5 mRNA levels were statistically significantly lower in ume6Δ pRS313 than in the wild-type strain (p < 0.01), the reductions in basal PDR15 and PDR5 mRNA levels in ume6Δ pRS313 were incompletely restored to wild-type pRS313 levels in ume6Δ pRS313–UME6 (p < 0.01) (Figure 3). The incomplete rescue by introduction of pRS313–UME6 into the ume6Δ mutant could result from nonphysiological levels of UME6 expression, because qRT–PCR revealed that UME6 is overexpressed at high levels—at least sevenfold—in ume6Δ pRS313–UME6 compared with wild-type pRS313. Regardless, this restoration of PDR15 and PDR5 mRNA levels suggests that the deletion of UME6 is a cause of reduced mRNA levels of PDR15 and PDR5 in the ume6Δ mutant.

Figure 3.
RPD3 and PDR3 are required for partial complementation of the reduction in PDR15 and PDR5 mRNA levels caused by exogenous UME6 expression in ρ0 cells of the ume6Δ mutant. Relative PDR15 and PDR5 mRNA levels in the logarithmic growth phase were determined in ρ0 cells of each strain by qRT–PCR. The wild-type strain transformed with an empty pRS313 plasmid is termed wild-type pRS313. The ume6Δ mutants transformed with an empty pRS313 plasmid or pRS313-UME6 are designated ume6Δ pRS313 or ume6Δ pRS313-UME6, respectively. The ume6Δrpd3Δ mutants transformed with an empty pRS313 plasmid or pRS313-UME6 are designated ume6Δrpd3Δ pRS313 or ume6Δrpd3Δ pRS313-UME6, respectively. The ume6Δpdr3Δ mutants transformed with an empty pRS313 plasmid or pRS313-UME6 are termed ume6Δpdr3Δ pRS313 or ume6Δpdr3Δ pRS313-UME6, respectively. two asterisks (**) indicate p values less than 0.01.
Next, we investigated whether RPD3 and PDR3 are required for the partial rescue of reduced mRNA levels of PDR15 and PDR5 in the ume6Δ mutant by exogenous expression of UME6. Although there was no significant difference in the mRNA levels of PDR15 and PDR5 between ume6Δ pRS313 and ume6Δrpd3Δ pRS313 (p > 0.05), no upregulation of PDR15 and PDR5 mRNA levels was detected in ume6Δrpd3Δ pRS313–UME6 compared to ume6Δrpd3Δ pRS313 (p > 0.05) (Figure 3). Similarly, there was no significant difference in the mRNA levels of PDR15 and PDR5 between ume6Δ pRS313 and ume6Δpdr3Δ pRS313 (p > 0.05), while the mRNA levels of PDR15 and PDR5 in ume6Δpdr3Δ pRS313–UME6 were not statistically significantly higher than those in ume6Δpdr3Δ pRS313 (p > 0.05) (Figure 3). These results indicate that RPD3 and PDR3 are required for incomplete rescue of the reduction in PDR15 and PDR5 mRNA levels in the ume6Δ mutant by exogenous expression of UME6.
3.3. RPD3 and PDR3 Are Required for Incomplete Restoration of Susceptibility to Fluconazole and Cycloheximide in the ume6Δ Strain via Exogeneous UME6 Expression
To examine whether exogeneous UME6 expression from a plasmid with a low copy number can rescue the susceptibility of ume6Δ mutant ρ0 cells to the PDR substrates fluconazole and cycloheximide, a spot dilution assay was carried out. We found that ume6Δ pRS313 displays greater susceptibility to fluconazole and cycloheximide than does wild-type pRS313 (Figure 4). In contrast, exogeneous UME6 expression in ume6Δ pRS313–UME6 incompletely rescued the susceptibility to fluconazole and cycloheximide in ume6Δ pRS313 (Figure 4). These results can be explained by the partial rescue of PDR15 and PDR5 reduction by exogenous UME6 expression in ume6Δ pRS313–UME6, as shown in Figure 3. This partial restoration of susceptibility to fluconazole and cycloheximide also suggests that the deletion of UME6 is a cause of high susceptibility to fluconazole and cycloheximide in the ume6Δ mutant.
Figure 4.
RPD3 and PDR3 are required for partial complementation of sensitivity to fluconazole and cycloheximide by exogenous UME6 expression in ρ0 cells of the ume6Δ mutant. Fluconazole or cycloheximide resistance in the ρ0 cells of the wild-type, ume6Δ, ume6Δrpd3Δ, and ume6Δpdr3Δ strains with an empty pRS313 plasmid or a pRS313-UME6 plasmid was determined by the spot dilution assay.
We next examined whether RPD3 and PDR3 are required for incomplete restoration of high susceptibility to fluconazole and cycloheximide in the ume6Δ mutant by exogenous UME6 expression. In contrast to the case of ume6Δ pRS313 and ume6Δ pRS313–UME6, high susceptibility to fluconazole and cycloheximide in ume6Δrpd3Δ pRS313 and ume6Δpdr3Δ pRS313 was not complemented with exogenous UME6 expression in ume6Δrpd3Δ pRS313–UME6 and ume6Δpdr3Δ pRS313–UME6 (Figure 4). These results suggest that Ume6-mediated activation of PDR in ρ0 cells is dependent on RPD3 and PDR3.
4. Discussion
In this report, we showed that UME6 and RPD3 are required for upregulating the steady-state mRNA expression of SNQ2, PDR15, and PDR5 in S. cerevisiae ρ0 cells. Although SNQ2, PDR15, PDR5, and PDR10 are activated by Pdr3 in ρ0 cells [50], the mRNA levels of SNQ2, PDR15, and PDR5 but not that of PDR10 were increased by Ume6 and Rpd3 in ρ0 cells (Figure 1 and Figure 2). Thus, Ume6 and Rpd3 may bind to the promoter regions of SNQ2, PDR15, and PDR5 but not to the promoter region of PDR10 and increase the transcription of SNQ2, PDR15, and PDR5 via Pdr3 in ρ0 cells. Although Ume6 is bound to the promoters of PDR5, PDR10, and YOR1 but not to that of SNQ2 or PDR15 in S. cerevisiae ρ+ cells, it is unknown whether Ume6 is localised at the SNQ2, PDR15, and PDR5 promoters in ρ0 cells [53,54]. Alternatively, the upregulation of SNQ2, PDR15, and PDR5 mRNA expression mediated by Rpd3 and Ume6 in ρ0 cells may be indirectly caused by changes in the expression of other genes. In addition, the expression of PDR10 was significantly lower in the ume6Δ strain but significantly greater in the rpd3Δ strain than in the wild-type strain (Figure 1 and Figure 2). This may be because Rpd3 deacetylates proteins involved in the regulation of PDR10 independent of Ume6.
In an example similar to the transcriptional regulation of SNQ2, PDR15, and PDR5 by Ume6 and Rpd3 in ρ0 cells, the histone chaperone Rtt106 specifically localises to the SNQ2, PDR15, and PDR5 promoters in a manner dependent on Pdr3 but not Pdr1 in S. cerevisiae ρ+ cells [54]. The histone chaperone Rtt106 is also essential for Pdr3-mediated basal expression of SNQ2, PDR15, and PDR5 in ρ+ cells [54]. In addition, PDR3 carrying the gain-of-function allele pdr3-7 in ρ+ cells has fewer target genes than Pdr3 activated by retrograde signalling in ρ0 cells [50]. These findings suggest that other transcription factors act in concert with Pdr3 in ρ0 cells. Therefore, the colocalisation of cooperative factors such as Ume6 and Rpd3 with Pdr3 at promoters may be required for the activation of target genes by Pdr3 in ρ0 cells.
We also revealed that Ume6 activates PDR15 and PDR5 transcription and PDR via RPD3 and PDR3 in ρ0 cells. Although it is currently unknown whether the histone deacetylase activity of Rpd3 is required for the activation of PDR15 and PDR5 transcription and PDR by retrograde signalling in ρ0 cells, histone deacetylation by Rpd3 can lead to the transcriptional activation of DNA damage-inducible and osmoresponsive genes [43,55]. Therefore, the histone deacetylase activity of Rpd3 recruited to the PDR15 and PDR5 promoters by Ume6 may activate the transcription of PDR15 and PDR5. Moreover, in an example similar to the dependency of UME6 on RPD3 and PDR3 for the activation of PDR15 and PDR5 transcription and PDR in ρ0 cells, PDR1 is required for the activation of PDR5 and YOR1 transcription by the C-terminal region of Zuo1 (Zuo1C) in ρ+ cells [56]. Zuo1, a ribosome-associated J protein, can positively regulate the transcription of PDR5 and YOR1, increasing the activity of the transcription factor Pdr1 when it is not bound to ribosomes [56]. Exogenous expression of Zuo1C increases the expression of reporter genes driven by the PDR5 or YOR1 promoter (PDR5–lacZ and YOR1–lacZ) in the order of 10- and 4-fold, respectively, in both wild-type cells and pdr3Δ cells [56]. In contrast, no activation of PDR5–lacZ or YOR1–lacZ was observed in pdr1Δ cells expressing Zuo1C [56]. In addition, similar levels of drug resistance were observed in wild-type and pdr3Δ cells expressing Zuo1C, whereas no drug resistance in the presence of the drug was observed in pdr1Δ cells [56]. Thus, Prunuske et al. concluded that Zuo1-mediated activation of PDR5, YOR1, and PDR is dependent on Pdr1 [56]. In addition, Hallstrom et al. investigated the dependency of PDR13 on PDR1 for PDR13-mediated induction of cycloheximide resistance in ρ+ cells using a spot assay [57]. Hallstrom et al. concluded that PDR1 is required for the induction of cycloheximide resistance by PDR13 in ρ+ cells [57]. These reports support the relevance of our approach in examining the dependency of UME6 on RPD3 and PDR3 for the activation of PDR15 and PDR5 transcription and PDR.
In addition, how Ume6 and Rpd3 are involved in the activation of PDR15 and PDR5 transcription and PDR by Pdr3 in ρ0 cells is unknown. It has been reported that the Rpd3 complex is required for the normal function of the transcriptional activator Upc2 and its stable binding to the promoter of the anaerobic gene DAN1 [44]. Therefore, Ume6 and Rpd3 may also localise to the PDR15 and PDR5 promoters in ρ0 cells and facilitate the normal function of Pdr3 and its stable binding to these promoter regions (Figure 5).

Figure 5.
Model of the correlation among Ume6, Rpd3, and Pdr3 and the activation of SNQ2, PDR15, and PDR5 in ρ0 cells. In this model, Ume6 recruits Rpd3 to the SNQ2, PDR15, and PDR5 promoter regions, and the histone deacetylase activity of Rpd3 facilitates the binding of Pdr3 to these promoter regions.
Currently, the relationships among the molecules required for the activation of ABC transporter genes in ρ0 cells are unknown. We revealed that UME6 activates basal PDR15 and PDR5 transcription and PDR in a manner dependent on RPD3 and PDR3 in ρ0 cells (Figure 3 and Figure 4). In contrast, we previously showed that UME6 suppresses basal PDR5 expression and PDR in ρ+ cells [46]. Med12 in the L-Mediator complex also contributes to the induction of PDR5 expression in ρ0 cells but not in ρ+ cells. The transcriptional mediator complex serves as the interface between gene-specific transcription factors and the RNA polymerase II machinery [58]. The L-Mediator complex in S. cerevisiae contains the core mediator complex and the Cdk8 subcomplex. The Cdk8 subcomplex is composed of Med12/Srb8, Med13/Srb9, the cyclin-dependent kinase Cdk8/Srb10, and cyclin C/Srb11 [59]. Pdr1 and Pdr3 can bind to the KIX domain of a mediator subunit called Med15/Gal11 of the L-Mediator complex [32]. Loss of Med12 from the Cdk8 complex completely suppresses the induction of PDR5 expression in ρ0 cells but not in ρ+ cells [29]. In addition, Lge1 is required for proper PDR5 induction in ρ0 cells but not in ρ+ cells, independent of its role in histone H2B ubiquitination [31]. These results indicate a difference in the regulatory machinery of PDR5 transcription between ρ+ and ρ0 cells. Thus, the identification of all molecules specifically required for the activation of ABC transporter genes and PDR in ρ0/− cells is needed to reveal the relationships among these molecules.
C. albicans and C. glabrata are the two most common yeast pathogens in humans [60,61]. S. cerevisiae is phylogenetically closer to C. glabrata than to C. albicans [62]. Loss of the mitochondrial genome also leads to increased PDR in C. glabrata [63]. However, C. albicans cannot survive the loss of mitochondrial DNA and therefore is petite negative [63]. The molecules involved in PDR pathway activation in S. cerevisiae ρ0 cells are parallel to those in C. glabrata ρ0 cells. For example, the Pdr3 homologue CgPdr1 in C. glabrata, upon compromise of mitochondrial function, upregulates the expression of CDR1 and CDR2, the homologues of S. cerevisiae PDR5 [64]. In addition, in C. glabrata ρ+ cells, the loss of the Rpd3 orthologue CgRpd3 increases susceptibility to caspofungin at high concentrations [65]. However, no mechanistic explanation—for example, gene targets or changes in histone modifications—has been provided for the caspofungin hypersensitive phenotype. Thus, the Ume6 orthologue Zcf11 in C. glabrata may also be responsible for multidrug resistance via transcriptional regulation of efflux genes. Therefore, identifying specific inhibitors of Zcf11 may lead to the development of drugs with activity against the multidrug-resistant pathogen C. glabrata.
5. Conclusions
We previously showed that RPD3 and UME6 are required for the activation of PDR5 and PDR in ρ0 cells. This study investigated the dependence of Ume6 on Rpd3 and Pdr3 in basal transcription of the ABC transporters, including PDR5, and PDR in S. cerevisiae ρ0 cells. Using a real-time PCR, RPD3 and UME6 were responsible for the activated basal expression of the ABC transporter-encoding genes SNQ2, PDR15, and PDR5 in S. cerevisiae ρ0 cells. Furthermore, Ume6 increased the basal expression of PDR5 and PDR15, and induced PDR in a manner dependent on RPD3 and PDR3 in ρ0 cells. This work may contribute to an elucidation of the relationships between molecules required for the activation of the ABC transporter genes in ρ0/− cells.
Supplementary Materials
The following supporting information can be downloaded at https://www.mdpi.com/article/10.3390/microbiolres15020048/s1: Table S1: Primers used for qRT–PCR.
Author Contributions
M.F., M.O. and Y.Y. performed experiments. M.F. and Y.Y. analysed data. Y.Y. made contributions to the conception, design, and drafting of the manuscript. All authors have read and agreed to the published version of the manuscript.
Funding
This research received no external funding.
Institutional Review Board Statement
Not applicable.
Informed Consent Statement
Not applicable.
Data Availability Statement
Data are contained within the article and Supplementary Materials.
Acknowledgments
We thank Jun Iwasaki at the School of Biological Science and Technology, Kanazawa University, for technical support.
Conflicts of Interest
The authors declare no conflicts of interest.
References
- Khunweeraphong, N.; Kuchler, K. Multidrug Resistance in Mammals and Fungi—From MDR to PDR: A Rocky Road from Atomic Structures to Transport Mechanisms. Int. J. Mol. Sci. 2021, 22, 4806. [Google Scholar] [CrossRef] [PubMed]
- Catalano, A.; Iacopetta, D.; Ceramella, J.; Scumaci, D.; Giuzio, F.; Saturnino, C.; Aquaro, S.; Rosano, C.; Sinicropi, M.S. Multidrug Resistance (MDR): A Widespread Phenomenon in Pharmacological Therapies. Molecules 2022, 27, 616. [Google Scholar] [CrossRef] [PubMed]
- Chang, Y.C.; Shieh, M.C.; Chang, Y.H.; Huang, W.L.; Su, W.C.; Cheng, F.Y.; Cheung, C.H.A. Development of a cancer cells self-activating and miR-125a-5p expressing poly-pharmacological nanodrug for cancer treatment. Int. J. Mol. Med. 2022, 50, 102. [Google Scholar] [CrossRef]
- Karthika, C.; Sureshkumar, R.; Zehravi, M.; Akter, R.; Ali, F.; Ramproshad, S.; Mondal, B.; Tagde, P.; Ahmed, Z.; Khan, F.S.; et al. Multidrug Resistance of Cancer Cells and the Vital Role of P-Glycoprotein. Life 2022, 12, 897. [Google Scholar] [CrossRef] [PubMed]
- Singh, S.; Gomez, H.J.; Thakkar, S.; Singh, S.P.; Parihar, A.S. Overcoming Acquired Drug Resistance to Cancer Therapies through Targeted STAT3 Inhibition. Int. J. Mol. Sci. 2023, 24, 4722. [Google Scholar] [CrossRef] [PubMed]
- Berman, J.; Krysan, D.J. Drug resistance and tolerance in fungi. Nat. Rev. Microbiol. 2020, 18, 319–331. [Google Scholar] [CrossRef] [PubMed]
- Osset-Trénor, P.; Pascual-Ahuir, A.; Proft, M. Fungal Drug Response and Antimicrobial Resistance. J. Fungi 2023, 9, 565. [Google Scholar] [CrossRef]
- Czajka, K.M.; Venkataraman, K.; Brabant-Kirwan, D.; Santi, S.A.; Verschoor, C.; Appanna, V.D.; Singh, R.; Saunders, D.P.; Tharmalingam, S. Molecular Mechanisms Associated with Antifungal Resistance in Pathogenic Candida Species. Cells 2023, 12, 2655. [Google Scholar] [CrossRef] [PubMed]
- Oyama, M.; Tamaki, H.; Yamaguchi, Y.; Ogita, A.; Tanaka, T.; Fujita, K.I. Deletion of the Golgi Ca2+-ATPase PMR1 gene potentiates antifungal effects of dodecanol that depend on intracellular Ca2+ accumulation in budding yeast. FEMS Yeast Res. 2020, 20, foaa003. [Google Scholar] [CrossRef]
- Song, J.; Zhou, J.; Zhang, L.; Li, R. Mitochondria-Mediated Azole Drug Resistance and Fungal Pathogenicity: Opportunities for Therapeutic Development. Microorganisms 2020, 8, 1574. [Google Scholar] [CrossRef]
- Demuyser, L.; Van Dijck, P. Can Saccharomyces cerevisiae keep up as a model system in fungal azole susceptibility research? Drug Resist. Updat. 2019, 42, 22–34. [Google Scholar] [CrossRef] [PubMed]
- Zhang, X.; Moye-Rowley, W.S. Saccharomyces cerevisiae multidrug resistance gene expression inversely correlates with the status of the F0 Component of the mitochondrial ATPase. J. Biol. Chem. 2001, 276, 47844–47852. [Google Scholar] [CrossRef] [PubMed]
- Decottignies, A.; Grant, A.M.; Nichols, J.W.; de Wet, H.; McIntosh, D.B.; Goffeau, A. ATPase and multidrug transport activities of the overexpressed yeast ABC protein Yor1p. J. Biol. Chem. 1998, 273, 12612–12622. [Google Scholar] [CrossRef] [PubMed]
- Carvajal, E.; Van Den Hazel, H.B.; Cybularz-Kolaczkowska, A.; Balzi, E.; Goffeau, A. Molecular and phenotypic: Characterization of yeast PDR1 mutants that show hyperactive transcription of various ABC multidrug transporter genes. Mol. Gen. Genet. 1997, 256, 406–415. [Google Scholar] [CrossRef] [PubMed][Green Version]
- Nourani, A.; Wesolowski-Louvel, M.; Delaveau, T.; Jacq, C.; Delahodde, A. Multiple-drug-resistance phenomenon in the yeast Saccharomyces cerevisiae: Involvement of two hexose transporters. Mol. Cell Biol. 1997, 17, 5453–5460. [Google Scholar] [CrossRef] [PubMed]
- Cui, Z.; Hirata, D.; Tsuchiya, E.; Osada, H.; Miyakawa, T. The multidrug resistance-associated protein (MRP) subfamily (Yrs1/Yor1) of Saccharomyces cerevisiae is important for the tolerance to a broad range of organic anions. J. Biol. Chem. 1996, 271, 14712–14716. [Google Scholar] [CrossRef] [PubMed]
- Mahé, Y.; Lemoine, Y.; Kuchler, K. The ATP binding cassette transporters Pdr5 and Snq2 of Saccharomyces cerevisiae can mediate transport of steroids in vivo. J. Biol. Chem. 1996, 271, 25167–25172. [Google Scholar] [CrossRef] [PubMed]
- Balzi, E.; Wang, M.; Leterme, S.; Van Dyck, L.; Goffeau, A. PDR5, a novel yeast multidrug resistance conferring transporter controlled by the transcription regulator PDR1. J. Biol. Chem. 1994, 269, 2206–2214. [Google Scholar] [CrossRef] [PubMed]
- Ueda, Y.; Tahara, Y.O.; Miyata, M.; Ogita, A.; Yamaguchi, Y.; Tanaka, T.; Fujita, K.I. Involvement of a Multidrug Efflux Pump and Alterations in Cell Surface Structure in the Synergistic Antifungal Activity of Nagilactone E and Anethole against Budding Yeast Saccharomyces cerevisiae. Antibiotics 2021, 10, 537. [Google Scholar] [CrossRef]
- Wolfger, H.; Mahé, Y.; Parle-McDermott, A.; Delahodde, A.; Kuchler, K. The yeast ATP binding cassette (ABC) protein genes PDR10 and PDR15 are novel targets for the Pdr1 and Pdr3 transcriptional regulators. FEBS Lett. 1997, 418, 269–274. [Google Scholar] [CrossRef]
- Katzmann, D.J.; Hallstrom, T.C.; Mahé, Y.; Moye-Rowley, W.S. Multiple Pdr1p/Pdr3p binding sites are essential for normal expression of the ATP binding cassette transporter protein-encoding gene PDR5. J. Biol. Chem. 1996, 271, 23049–23054. [Google Scholar] [CrossRef] [PubMed]
- Delahodde, A.; Delaveau, T.; Jacq, C. Positive autoregulation of the yeast transcription factor Pdr3p, which is involved in control of drug resistance. Mol. Cell. Biol. 1995, 15, 4043–4051. [Google Scholar] [CrossRef] [PubMed]
- Delaveau, T.; Delahodde, A.; Carvajal, E.; Subik, J.; Jacq, C. PDR3, a new yeast regulatory gene, is homologous to PDR1 and controls the multidrug resistance phenomenon. Mol. Gen. Genet. 1994, 244, 501–511. [Google Scholar] [CrossRef]
- DeRisi, J.; van den Hazel, B.; Marc, P.; Balzi, E.; Brown, P.; Jacq, C.; Goffeau, A. Genome microarray analysis of transcriptional activation in multidrug resistance yeast mutants. FEBS Lett. 2000, 470, 156–160. [Google Scholar] [CrossRef]
- Plocek, V.; Fadrhonc, K.; Maršíková, J.; Váchová, L.; Pokorná, A.; Hlaváček, O.; Wilkinson, D.; Palková, Z. Mitochondrial Retrograde Signaling Contributes to Metabolic Differentiation in Yeast Colonies. Int. J. Mol. Sci. 2021, 22, 5597. [Google Scholar] [CrossRef] [PubMed]
- Gorospe, C.M.; Carvalho, G.; Herrera Curbelo, A.; Marchhart, L.; Mendes, I.C.; Niedźwiecka, K.; Wanrooij, P.H. Mitochondrial membrane potential acts as a retrograde signal to regulate cell cycle progression. Life Sci. Alliance 2023, 6, e202302091. [Google Scholar] [CrossRef]
- Hallstrom, T.C.; Moye-Rowley, W.S. Multiple signals from dysfunctional mitochondria activate the pleiotropic drug resistance pathway in Saccharomyces cerevisiae. J. Biol. Chem. 2000, 275, 37347–37356. [Google Scholar] [CrossRef]
- Shahi, P.; Gulshan, K.; Moye-Rowley, W.S. Negative transcriptional regulation of multidrug resistance gene expression by an Hsp70 protein. J. Biol. Chem. 2007, 282, 26822–26831. [Google Scholar] [CrossRef]
- Shahi, P.; Gulshan, K.; Näär, A.M.; Moye-Rowley, W.S. Differential Roles of Transcriptional Mediator Subunits in Regulation of Multidrug Resistance Gene Expression in Saccharomyces cerevisiae. Mol. Biol. Cell 2010, 21, 2469–2482. [Google Scholar] [CrossRef][Green Version]
- Gulshan, K.; Schmidt, J.A.; Shahi, P.; Moye-Rowley, W.S. Evidence for the bifunctional nature of mitochondrial phosphatidylserine decarboxylase: Role in Pdr3-dependent retrograde regulation of PDR5 expression. Mol. Cell Biol. 2008, 28, 5851–5864. [Google Scholar] [CrossRef]
- Zhang, X.; Kolaczkowska, A.; Devaux, F.; Panwar, S.L.; Hallstrom, T.C.; Jacq, C.; Moye-Rowley, W.S. Transcriptional regulation by Lge1p requires a function independent of its role in histone H2B ubiquitination. J. Biol. Chem. 2005, 280, 2759–2770. [Google Scholar] [CrossRef] [PubMed]
- Paul, S.; Moye-Rowley, W.S. Multidrug resistance in fungi: Regulation of transporter-encoding gene expression. Front. Physiol. 2014, 5, 143. [Google Scholar] [CrossRef]
- Robbins, N.; Leach, M.D.; Cowen, L.E. Lysine Deacetylases Hda1 and Rpd3 Regulate Hsp90 Function thereby Governing Fungal Drug Resistance. Cell Rep. 2012, 2, 878–888. [Google Scholar] [CrossRef] [PubMed]
- Rundlett, S.E.; Carmen, A.A.; Suka, N.; Turner, B.M.; Grunstein, M. Transcriptional repression by UME6 involves deacetylation of lysine 5 of histone H4 by RPD3. Nature 1998, 392, 831–835. [Google Scholar] [CrossRef] [PubMed]
- Goldmark, J.P.; Fazzio, T.G.; Estep, P.W.; Church, G.M.; Tsukiyama, T. The Isw2 chromatin remodeling complex represses early meiotic genes upon recruitment by Ume6p. Cell 2000, 103, 423–433. [Google Scholar] [CrossRef] [PubMed]
- Patel, A.B.; Qing, J.; Tam, K.H.; Zaman, S.; Luiso, M.; Radhakrishnan, I.; He, Y. Cryo-EM structure of the Saccharomyces cerevisiae Rpd3L histone deacetylase complex. Nat. Commun. 2023, 14, 3061. [Google Scholar] [CrossRef] [PubMed]
- Carrozza, M.J.; Florens, L.; Swanson, S.K.; Shia, W.J.; Anderson, S.; Yates, J.; Washburn, M.P.; Workman, J.L. Stable incorporation of sequence specific repressors Ash1 and Ume6 into the Rpd3L complex. Biochim. Biophys. Acta 2005, 1731, 77–87. [Google Scholar] [CrossRef] [PubMed]
- David, K.; Kevin, S. Repression by Ume6 involves recruitment of a complex containing Sin3 corepressor and Rpd3 histone deacetylase to target promoters. Cell 1997, 89, 365–371. [Google Scholar]
- Strich, R.; Surosky, R.T.; Steber, C.; Dubois, E.; Messenguy, F.; Esposito, R.E. UME6 is a key regulator of nitrogen repression and meiotic development. Genes Dev. 1994, 8, 796–810. [Google Scholar] [CrossRef]
- Fazzio, T.G.; Kooperberg, C.; Goldmark, J.P.; Neal, C.; Basom, R.; Delrow, J.; Tsukiyama, T. Widespread collaboration of Isw2 and Sin3-Rpd3 chromatin remodeling complexes in transcriptional repression. Mol. Cell Biol. 2001, 21, 6450–6460. [Google Scholar] [CrossRef]
- Kadosh, D.; Struhl, K. Targeted recruitment of the Sin3-Rpd3 histone deacetylase complex generates a highly localized domain of repressed chromatin in vivo. Mol. Cell Biol. 1998, 18, 5121–5127. [Google Scholar] [CrossRef] [PubMed]
- Harris, A.; Ünal, E. The transcriptional regulator Ume6 is a major driver of early gene expression during gametogenesis. Genetics 2023, 225, iyad123. [Google Scholar] [CrossRef]
- De Nadal, E.; Zapater, M.; Alepuz, P.M.; Sumoy, L.; Mas, G.; Posas, F. The MAPK Hog1 recruits Rpd3 histone deacetylase to activate osmoresponsive genes. Nature 2004, 427, 370–374. [Google Scholar] [CrossRef]
- Sertil, O.; Vemula, A.; Salmon, S.L.; Morse, R.H.; Lowry, C.V. Direct role for the Rpd3 complex in transcriptional induction of the anaerobic DAN/TIR genes in yeast. Mol. Cell Biol. 2007, 27, 2037–2047. [Google Scholar] [CrossRef]
- Yamada, Y. RPD3 and UME6 are involved in the activation of PDR5 transcription and pleiotropic drug resistance in ρ0 cells of Saccharomyces cerevisiae. BMC Microbiol. 2021, 21, 311. [Google Scholar] [CrossRef]
- Yamada, Y. UME6 Is Involved in the Suppression of Basal Transcription of ABC Transporters and Drug Resistance in the ρ+ Cells of Saccharomyces cerevisiae. Microorganisms 2022, 10, 601. [Google Scholar] [CrossRef] [PubMed]
- Onda, M.; Ota, K.; Chiba, T.; Sakaki, Y.; Ito, T. Analysis of gene network regulating yeast multidrug resistance by artificial activation of transcription factors: Involvement of Pdr3 in salt tolerance. Gene 2004, 332, 51–59. [Google Scholar] [CrossRef] [PubMed]
- Czarnecka, M.; Połomska, X.; Restuccia, C.; Żarowska, B. The Role of Plasma Membrane Pleiotropic Drug Resistance Transporters in the Killer Activity of Debaryomyces hansenii and Wickerhamomyces anomalus Toxins. Toxins 2022, 14, 180. [Google Scholar] [CrossRef]
- Yamada, Y.; Shiroma, A.; Hirai, S.; Iwasaki, J. Zuo1, a ribosome-associated J protein, is involved in glucose repression in Saccharomyces cerevisiae. FEMS Yeast Res. 2023, 23, foad038. [Google Scholar] [CrossRef]
- Devaux, F.; Carvajal, E.; Moye-Rowley, S.; Jacq, C. Genome-wide studies on the nuclear PDR3-controlled response to mitochondrial dysfunction in yeast. FEBS Lett. 2002, 515, 25–28. [Google Scholar] [CrossRef]
- Sikorski, R.S.; Hieter, P. A system of shuttle vectors and yeast host strains designed for efficient manipulation of DNA in Saccharomyces cerevisiae. Genetics 1989, 122, 19–27. [Google Scholar] [CrossRef]
- Yamada, Y.; Sasaki, S. A method for identifying allele-specific hydroxymethylation. Epigenetics 2020, 15, 231–250. [Google Scholar] [CrossRef]
- Venters, B.J.; Wachi, S.; Mavrich, T.N.; Andersen, B.E.; Jena, P.; Sinnamon, A.J.; Jain, P.; Rolleri, N.S.; Jiang, C.; Hemeryck-Walsh, C.; et al. A Comprehensive Genomic Binding Map of Gene and Chromatin Regulatory Proteins in Saccharomyces. Mol. Cell 2011, 41, 480–492. [Google Scholar] [CrossRef]
- Nikolov, V.N.; Malavia, D.; Kubota, T. SWI/SNF and the histone chaperone Rtt106 drive expression of the Pleiotropic Drug Resistance network genes. Nat. Commun. 2022, 13, 1968. [Google Scholar] [CrossRef]
- Sharma, V.M.; Tomar, R.S.; Dempsey, A.E.; Reese, J.C. Histone deacetylases RPD3 and HOS2 regulate the transcriptional activation of DNA damage-inducible genes. Mol. Cell Biol. 2007, 27, 3199–3210. [Google Scholar] [CrossRef]
- Prunuske, A.J.; Waltner, J.K.; Kuhn, P.; Gu, B.; Craig, E.A. Role for the molecular chaperones Zuo1 and Ssz1 in quorum sensing via activation of the transcription factor Pdr1. Proc. Natl. Acad. Sci. USA 2012, 109, 472–477. [Google Scholar] [CrossRef]
- Hallstrom, T.C.; Katzmann, D.J.; Torres, R.J.; Sharp, W.J.; Moye-Rowley, W.S. Regulation of transcription factor Pdr1p function by an Hsp70 protein in Saccharomyces cerevisiae. Mol. Cell Biol. 1998, 18, 1147–1155. [Google Scholar] [CrossRef]
- Horvath, R.; Hawe, N.; Lam, C.; Mestnikov, K.; Eji-Lasisi, M.; Rohde, J.; Sadowski, I. TORC1 signaling modulates Cdk8-dependent GAL gene expression in Saccharomyces cerevisiae. Genetics 2021, 219, iyab168. [Google Scholar] [CrossRef]
- Elmlund, H.; Baraznenok, V.; Lindahl, M.; Samuelsen, C.O.; Koeck, P.J.; Holmberg, S.; Hebert, H.; Gustafsson, C.M. The cyclin-dependent kinase 8 module sterically blocks Mediator interactions with RNA polymerase II. Proc. Natl. Acad. Sci. USA 2006, 103, 15788–15793. [Google Scholar] [CrossRef]
- Andrade-Pavón, D.; Sánchez-Sandoval, E.; Tamariz, J.; Ibarra, J.A.; Hernández-Rodríguez, C.; Villa-Tanaca, L. Inhibitors of 3-Hydroxy-3-methylglutaryl Coenzyme A Reductase Decrease the Growth, Ergosterol Synthesis and Generation of petite Mutants in Candida glabrata and Candida albicans. Int. J. Mol. Sci. 2023, 24, 16868. [Google Scholar] [CrossRef]
- Bedekovic, T.; Usher, J. Is There a Relationship Between Mating and Pathogenesis in Two Human Fungal Pathogens, Candida albicans and Candida glabrata? Curr. Clin. Microbiol. Rep. 2023, 10, 47–54. [Google Scholar] [CrossRef]
- Roetzer, A.; Gabaldón, T.; Schüller, C. From Saccharomyces cerevisiae to Candida glabrata in a few easy steps: Important adaptations for an opportunistic pathogen. FEMS Microbiol. Lett. 2011, 314, 1–9. [Google Scholar] [CrossRef] [PubMed]
- Verma, S.; Shakya, V.P.S.; Idnurm, A. Exploring and exploiting the connection between mitochondria and the virulence of human pathogenic fungi. Virulence 2018, 9, 426–446. [Google Scholar] [CrossRef]
- Paul, S.; Schmidt, J.A.; Moye-Rowley, W.S. Regulation of the CgPdr1 transcription factor from the pathogen Candida glabrata. Eukaryot. Cell 2011, 10, 187–197. [Google Scholar] [CrossRef] [PubMed]
- Baker, K.M.; Hoda, S.; Saha, D.; Gregor, J.B.; Georgescu, L.; Serratore, N.D.; Zhang, Y.; Cheng, L.; Lanman, N.A.; Briggs, S.D. The Set1 Histone H3K4 Methyltransferase Contributes to Azole Susceptibility in a Species-Specific Manner by Differentially Altering the Expression of Drug Efflux Pumps and the Ergosterol Gene Pathway. Antimicrob. Agents Chemother. 2022, 66, e0225021. [Google Scholar] [CrossRef]
Disclaimer/Publisher’s Note: The statements, opinions and data contained in all publications are solely those of the individual author(s) and contributor(s) and not of MDPI and/or the editor(s). MDPI and/or the editor(s) disclaim responsibility for any injury to people or property resulting from any ideas, methods, instructions or products referred to in the content. |
© 2024 by the authors. Licensee MDPI, Basel, Switzerland. This article is an open access article distributed under the terms and conditions of the Creative Commons Attribution (CC BY) license (https://creativecommons.org/licenses/by/4.0/).